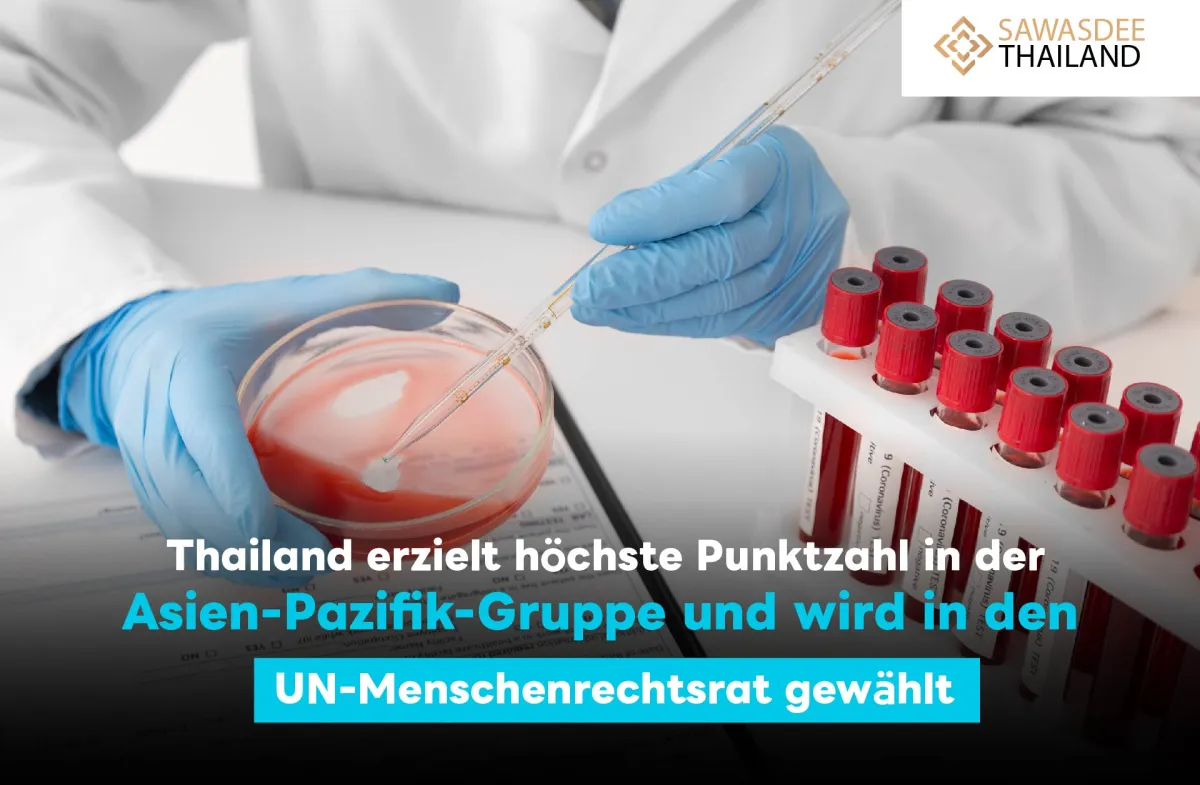

Thailand erzielt höchste Punktzahl in der Asien-Pazifik-Gruppe und wird in den UN-Menschenrechtsrat gewählt
Thailand wurde als Mitglied des Menschenrechtsrats der Vereinten Nationen (UNHRC) für die Amtszeit 2025-2027 gewählt. Bei der Wahl in der UN-Generalversammlung erhielt Thailand 177 Stimmen, die höchste Punktzahl in der Asien-Pazifik-Gruppe, und damit sein bisher bestes Ergebnis, das das Land jemals erzielt hat.
Thailand wird seine Arbeit als UNHRC-Mitglied am 1. Januar 2025 aufnehmen und eine dreijährige Amtszeit antreten. Es wird zusammen mit 17 weiteren Ländern wie Benin, Bolivien, Kolumbien, Zypern, Tschechien und der Schweiz tätig sein.
Die thailändische Regierung ist überzeugt, dass die Teilnahme am UNHRC zur Verbesserung der Menschenrechtsstandards auf nationaler und internationaler Ebene beitragen und das internationale Ansehen Thailands stärken wird. Diese Wahl bietet Thailand die Möglichkeit, eine Schlüsselrolle bei der Förderung von Menschenrechtsfragen zu übernehmen. Die Regierung bekräftigt ihr Engagement, eng mit anderen Mitgliedsländern zusammenzuarbeiten, um globale Menschenrechtsprobleme zu lösen.
Die Teilnahme am UNHRC wird nicht nur die Menschenrechte in Thailand stärken, sondern auch die Zusammenarbeit zwischen den Nationen fördern, um gleiche Rechte und Freiheiten für alle zu gewährleisten. Die thailändische Regierung wird weiterhin an einer gerechten und fairen Gesellschaft für alle Menschen im In- und Ausland arbeiten.
Weitere Informationen: Außenministerium
Link: https://www.mfa.go.th/




